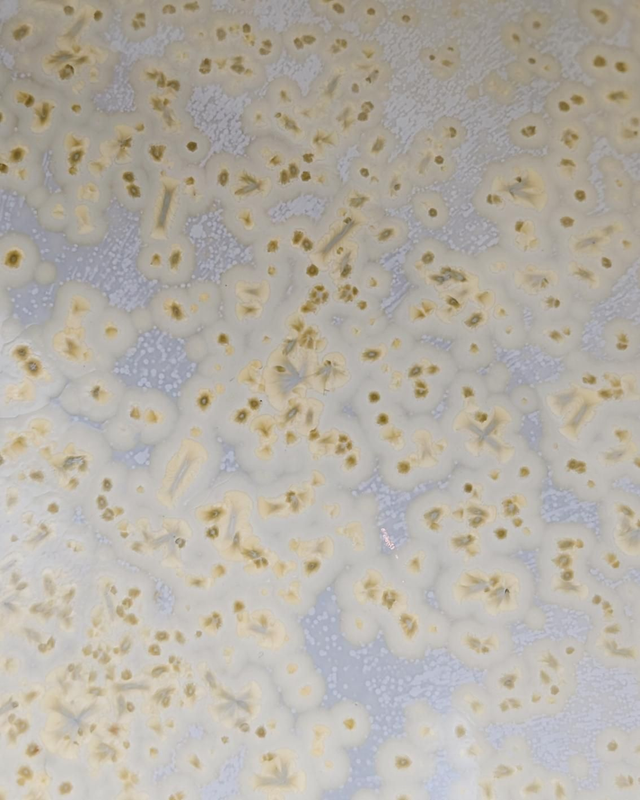

Zestaw katakuchi, chasentate i chasen "szalka Petriego"
219,00 zł
Nazwa "katakuchi" dosłownie oznacza "jednostronne usta" – i właśnie tym wyróżnia się to naczynie. Posiada dziubek, który ułatwia precyzyjne przelewanie naparu. Jest wprost stworzone do przygotowywania napojów na bazie matchy.
Do zestawu dołącza chasentate i dość nietypowy na polskim rynku chasen. Chasen ma drobne, elastyczne włoski i nieco mniejszy rozmiar niż standardowe. Ułatwia uzyskanie idealnej pianki.
Katakuchi
Pojemność: 400 ml
Waga: 337 g
Średnica: 12,5 cm
Wysokość: 7,8 cm
Chasentate
Wysokość: 6,1 cm
Średnica brzuszka: 5,9 cm
Chasen
Wysokość: 11,5 cm
Średnica: 6,0 cm
Kolory widoczne na zdjęciach mogą odbiegać od rzeczywistych - zależy to od ustawień monitora.
Produkt wykonany z materiałów bezpiecznych do kontaktu z żywnością.
Bezpieczny do mycia w zmywarce, jednak zalecam mycie ręczne delikatnymi środkami myjącymi.
Unikać nagłych zmian temperatury, aby zapobiec pęknięciu.

Udostępnij